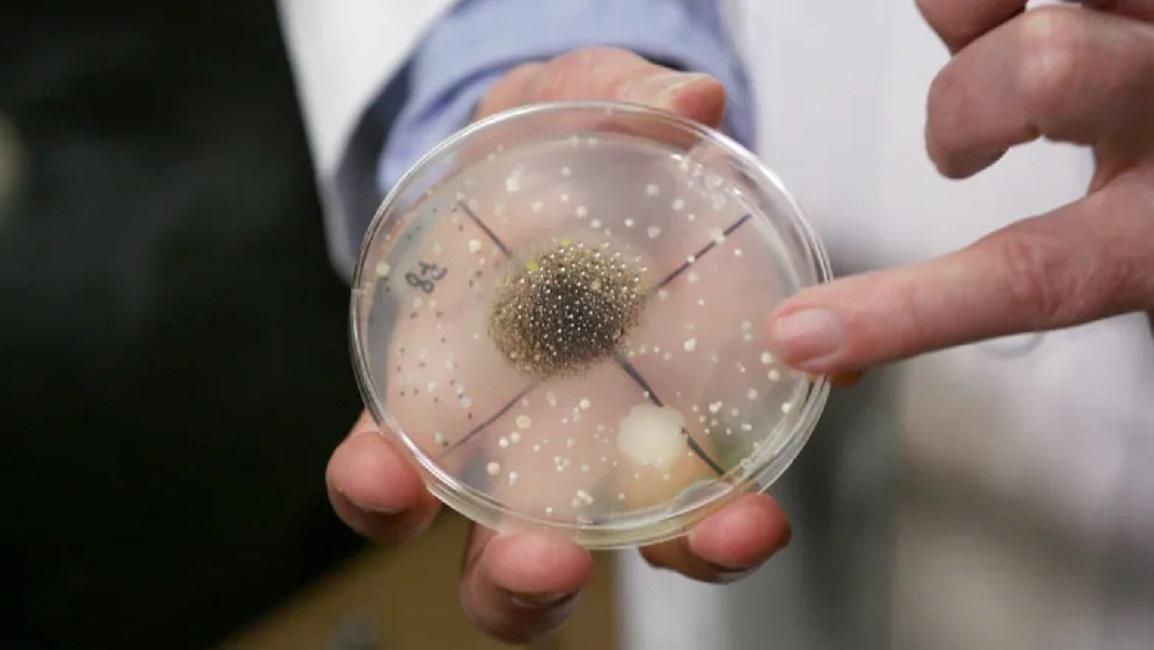
比如对容易滋生细菌的地方涂上化合物,二氧化钛通常会作为一种表面

细菌 滋生

夏季细菌易滋生做肛肠治疗会不会更易感染
图片尺寸587x358
内脏滋生3万种细菌
图片尺寸600x450
夏日细菌易滋生,索奇消毒柜变健康守护神
图片尺寸800x450
无惧春季细菌滋生,无机涂料长效增"墙"健康
图片尺寸600x428
夏天细菌病毒滋生,想给家里消消毒,选什么好呢?
图片尺寸750x440
你了解你的家里每天会滋生多少细菌吗
图片尺寸1080x1080
壹邦健康知识:有什么食物最容易滋生细菌?
图片尺寸640x640
厨房最易滋生细菌的十个重灾区
图片尺寸533x300
新品|一款细菌0滋生的条装化毛膏
图片尺寸790x1047
但殊不知,生活中有些食物,很容易滋生细菌病毒,如果不注意的话,也会对
图片尺寸1200x764
0度天气皮肤滋生细菌的真正原因听专家怎么说
图片尺寸640x353
夏季细菌易滋生,饮食不洁泻痢方
图片尺寸630x418
春季细菌滋生期你家的消毒杀菌做好了吗
图片尺寸640x423
细菌滋生需要几个必要的条件↓↓↓第一:需要营养物质.
图片尺寸1024x724
春季细菌滋生,汽车内的细菌数量竟然是厕所的10倍!
图片尺寸640x480
过夜酸梅汤会滋生许多细菌
图片尺寸1000x750
细菌滋生女性生殖健康
图片尺寸1440x1054
夏季气温高容易滋生细菌,再加上宝宝的肠 - 抖音
图片尺寸1170x1540
比如对容易滋生细菌的地方涂上化合物,二氧化钛通常会作为一种表面
图片尺寸1154x650
细菌家里哪些地方细菌滋生严重不看不知道一看吓一跳
图片尺寸900x1598